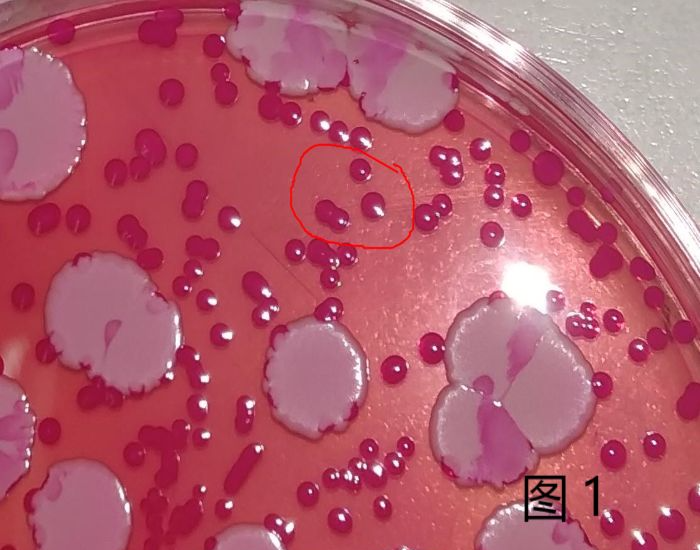
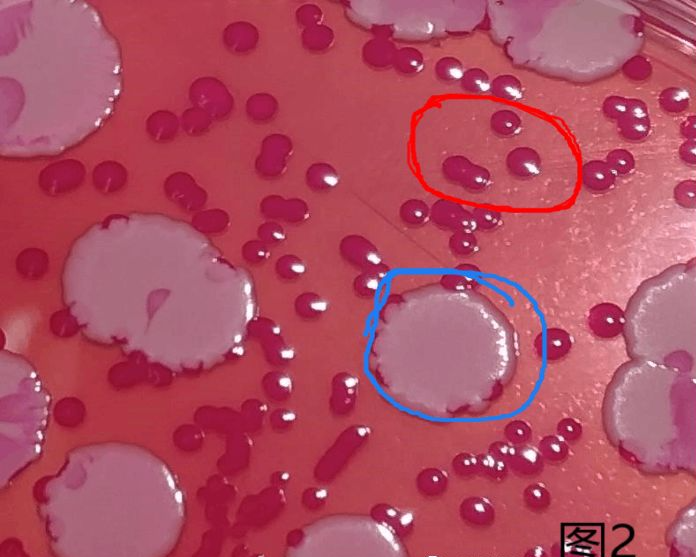
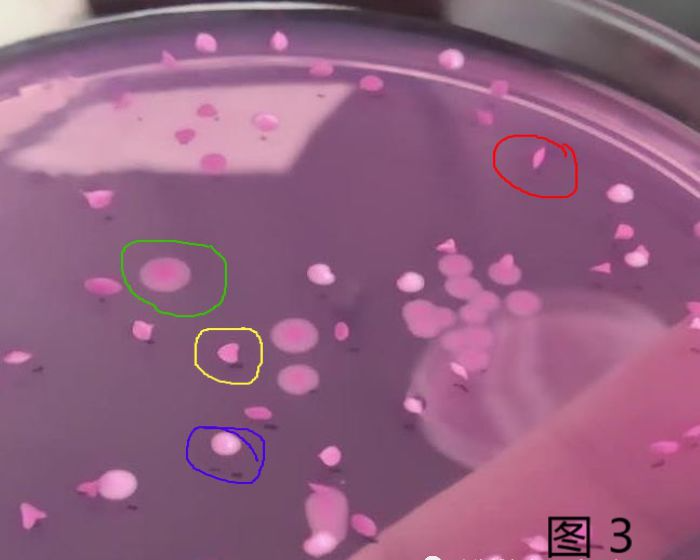

霉菌和酵母检测怎么鉴定?标准方法与快检有哪些不同?
发布时间:2023-06-16 浏览次数:3264
霉菌和酵母的检测是我们食品微生物检测的一个重要项目。霉菌是丝状真菌的俗称,绒毛状、絮状或蛛网状的真菌菌落;没有菌丝的称之为酵母。这并非分类学名词。
相对于细菌来说,霉菌和酵母生长缓慢,竞争能力较弱,故培养霉菌和酵母时要注意形成抑制细菌的环境。
下面是我们在检测霉菌酵母时遇到的几个问题:
1、计数前的鉴定
计数霉菌酵母结果前是需要鉴定菌落是否是真菌的。
霉菌的形态相对比较明显,不容易被混淆。但是对于酵母来说,培养基里抑制细菌的成分,例如氯霉素在此的剂量不足以抑制所有的细菌种类。部分细菌会在孟加拉红培养基上生长的也很好,如下图:
被红色圆圈圈起来的菌落是不是很像酵母?然而这只是一种革兰氏阳性的球菌而已,是细菌。
简单来说,真菌比细菌大得多。镜检如果使用低倍镜(10-40倍)就可以清晰观察到菌的轮廓,那么就是真菌。相反,如果需要油镜等高倍镜(1000倍以上),那就是细菌。
2、不同形态的菌落做镜检
“不同”形态的菌落,这个“不同”也是有区别的。如下图所示:
图2中红色和蓝色圆圈内的这两种“不同”形态的菌落,差别太大,确实是不相同的种类。
图3中的四个“不同”的形态的菌落,其实是同一种酵母,这是酿酒酵母菌的标准菌株在孟加拉红培养基上因为生长位置不同而体现出的差异。生长在琼脂表面的菌落,白色透粉红、圆形;生长在琼脂内部的菌落,出现菱形或花瓣形;生长在琼脂底部和平皿接触面上的菌落,呈现出较深粉红色的圆形。
使用倾注法,同一种酵母可能会出现不同的形态。因此,挑取有代表性的菌落做镜检,我们要慎之又慎。不然会做重复工作或漏检。
3、是否必须培养5天
在GB 4789.15-2016 中把“培养 5d,观察并记录”修改为“观察并记录培养至第 5d 的结果。”
部分霉菌适宜生长的温度稍高,如烟曲霉等,如果依然使用28℃培养,酶的催化活性降低,代谢速度减慢,繁殖就会慢,就不能提前计数。还有几类霉菌:毛霉、犁头霉、木霉等生长快、菌丝多,最好在48小时以内计数,否则菌丝就会覆盖整个平皿,无法准确计数。
另外,有的菌株如果培养时间不足,形态特征会不明显,不容易区分鉴别,因此需要延长培养时间。
4、标准方法与快检方法相比
依据GB 4789.15-2016 ,食品实验室检测霉菌酵母的时间在很多情况下显得过长,这也是近年来快速检测方法需求大增的原因。很多实验室在进行快检产品验收时,通过对比实验,发现使用黑曲霉菌和酿酒酵母菌,在孟加拉红琼脂上生长速度也很快,大约2-3天就可以报告结果,和一些快检方法相当。
《GB 4789.28-2013 食品微生物学检验 培养基和试剂的质量要求》附录E中要求,实验室常备验收孟加拉红琼脂或马铃薯葡萄糖培养基所使用的霉菌酵母的标准菌株为黑曲霉菌和酿酒酵母菌,因此大部分实验室如果做国标法和快检方法的对比实验,往往使用的也是这两种菌株。
但是我们要知道,GB 4789.28-2013 中附录E,半定量质控评定标准G值所采用的质控菌株(目标菌),生长繁殖速度相对较快,特征明显。以酿酒酵母菌为例,如果对纯菌液样液(无抑制成分、无干扰菌)倾注孟加拉红琼脂,28℃下培养48-72h就足以计数,继续培养也不过是使菌落变的更大。如果培养温度升高1-2℃,这一速度还将更快。同理,黑曲霉菌3天也已经足够。
现有的类似培养基培养的快检方法,如环凯Handy plate 快速霉菌酵母测试片,或者Biokar霉酵快速显色培养基等检测霉酵的时间大都为2-3天,这样一来,对比实验结果往往在培养2-3天后就可以全部观察到,会给人造成一种错觉:经过国际权威组织认证的快速检测方法,检测时间和孟加拉红琼脂差不多,那么日常检测中,培养了3天左右的孟加拉红琼脂上未长菌,是不是就可以下结论了呢?
实际上,培养了3天左右的孟加拉红琼脂上未长菌,在第四天或第五天开始出现霉菌酵母的情况是存在的。
以《SN/T 3266食品微生物检验方法确认技术规范》为例,对非标方法(定量)选择性的要求就包括:包容性≥98% (30个目标菌株),并不能以某种菌株的结果代表所有情况。
在本文前面已经提到,霉菌酵母的种类非常之多,GB 4789.15中将培养时间定在5天,也是考虑到在此培养条件下生长繁殖比较缓慢的情况。除少情形(培养时间过长会导致蔓延等)外,培养时间一定要足够。
来源:食品论坛网友分享,封面图来源创客贴会员,食品微生物检测小编整理。
转载只为分享目的,如有侵权或不愿小编转载发布请联系删除,谢谢!
